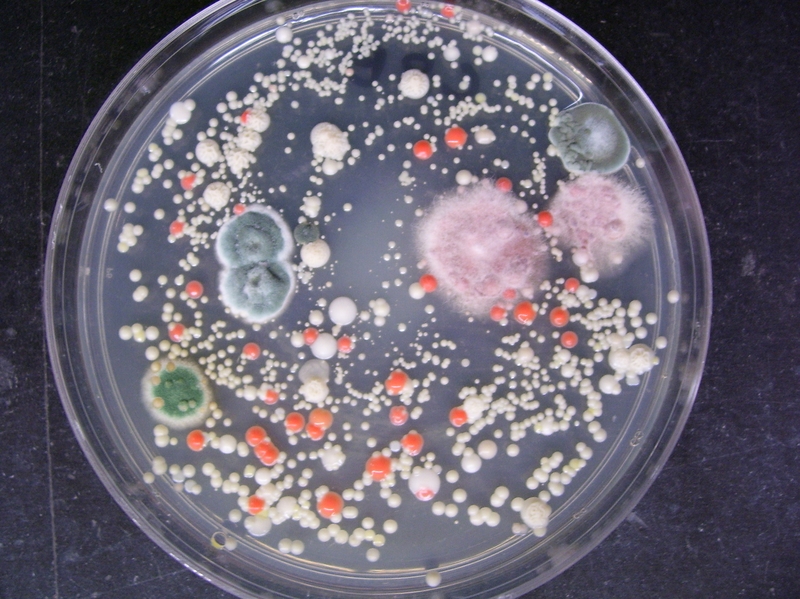
Nhiễm khuẩn ổ bụng: Nguyên nhân, triệu chứng và cách khắc phục 2

Dược sĩ Đại học có nhiều năm kinh nghiệm trong việc tư vấn Dược phẩm và hỗ trợ giải đáp thắc mắc về Bệnh học. Hiện đang là giảng viên cho Dược sĩ tại Nhà thuốc Long Châu.
Chí Doanh
29/03/2024
Mặc định
Lớn hơn
Nhiễm khuẩn ổ bụng là trường hợp cấp cứu ngoại khoa phổ biến và là nguyên nhân chính gây tử vong tại các bệnh viện trên toàn thế giới. Bệnh do nhiều yếu tố ảnh hưởng gây ra, đó là những yếu tố nào?, dấu hiệu nhận biết và điều trị như thế nào?, sẽ được giải đáp trong bài viết dưới đây.
Bệnh nhân ở ICU thường mắc nhiều bệnh lý nền khác nhau và nhiễm khuẩn ổ bụng là một bệnh truyền nhiễm phổ biến ở đối tượng này với tỷ lệ tử vong cao. So với các bệnh nhiễm trùng khác, nhiễm khuẩn ổ bụng có nhiều khả năng cao liên quan đến sốc nhiễm trùng và tổn thương thận cấp tính. Để hiểu rõ hơn về căn bệnh này thì hãy cùng Long Châu tìm hiểu qua bài viết này.
Nhiễm khuẩn ổ bụng là một loại nhiễm trùng liên quan đến chăm sóc sức khỏe phổ biến và là biến chứng thường gặp khi nhập viện. Nó là nguyên nhân khiến thời gian nằm viện kéo dài, tăng số lần tái nhập viện sau phẫu thuật. Phần lớn các trường hợp nhiễm khuẩn ổ bụng liên quan đến một cơ quan trong khoang bụng (viêm túi mật cấp tính, viêm ruột thừa cấp tính,...), viêm phúc mạc, áp xe ổ bụng, nhiễm trùng tuyến tụy và là nguyên nhân phổ biến gây nhiễm trùng huyết, thường xảy ra ở bệnh nhân được chăm sóc đặc biệt (ICU)
Nhiễm khuẩn ổ bụng đặc trưng bởi sự xâm nhập hay tăng lên quá mức của nhiều loại vi khuẩn như vi khuẩn gram dương, vi khuẩn gram âm, vi khuẩn kị khí (Bacteroides và loài Clostridium), vi khuẩn hiếu khí (Escherichia coli và Enterococcus), Pseudomonas aeruginosa, nấm,... Nguyên nhân khiến vi khuẩn xâm nhập hay tăng vượt mức bình thường có thể đến từ chấn thương xuyên bụng do tai nạn, phẫu thuật vùng bụng, viêm túi thừa, viêm ruột thừa, viêm tụy, bệnh đường mật, thủng tạng rỗng, viêm phúc mạc,...
Có nhiều yếu tố có thể làm tăng nguy cơ nhiễm khuẩn ổ bụng của bệnh nhân bao gồm tuổi tác, bệnh đi kèm, thói quen hút thuốc, béo phì, suy dinh dưỡng, ức chế miễn dịch, khối u ác tính và mức độ nhiễm trùng của vết thương.
Các biểu hiện lâm sàng của nhiễm khuẩn ổ bụng sẽ khác nhau tùy vào vị trí và mức độ nhiễm trùng. Bệnh nhân nhiễm khuẩn ổ bụng thường có biểu hiện điển hình là sốt, nôn mửa, đau bụng dữ dội, tiêu chảy, căng cơ bụng và chảy mủ bụng. Nhiễm khuẩn ổ bụng do bệnh lý tại các vị trí cụ thể thường có dấu hiệu đặc trưng; ví dụ, viêm túi thừa thường đau bụng dưới bên trái, táo bón, sốt, tăng bạch cầu,...; viêm ruột thừa thường đau quặn quanh rốn hoặc trên, đau truyền xuống vùng bụng dưới bên phải.
Nhiễm khuẩn ổ bụng có thể dẫn đến rối loạn huyết động, hô hấp, vi tuần hoàn và chuyển hóa của cơ thể, nếu không được điều trị kịp thời có thể phát triển thành nhiễm trùng huyết, sốc nhiễm trùng và thậm chí là suy đa cơ quan.

Chỉ dựa vào các dấu hiệu lâm sàng là chưa đủ cơ sở xác định là nhiễm khuẩn ổ bụng. Bệnh nhân cần thực hiện thêm các xét nghiệm như protein phản ứng C (CRP) và procalcitonin (PCT), siêu âm và chụp cắt lớp vi tính (CT) để hoàn thành việc đánh giá lâm sàng bệnh nhân nhiễm khuẩn ổ bụng.
Nhiễm trùng trong ổ bụng đặt ra một số thách thức lâm sàng cụ thể. Đầu tiên, có rất nhiều mức độ nghiêm trọng của bệnh, từ những trường hợp không biến chứng đến sốc nhiễm trùng kịch phát và rối loạn chức năng đa cơ quan. Cho nên, nền tảng của việc điều trị nhiễm khuẩn ổ bụng hiệu quả bao gồm nhận biết sớm, kiểm soát nguồn bệnh đầy đủ, liệu pháp kháng khuẩn thích hợp và ổn định sinh lý kịp thời bằng cách sử dụng môi trường chăm sóc tích cực, kết hợp với phương pháp phẫu thuật tối ưu.

Tóm lại, nhiễm khuẩn ổ bụng là một bệnh nguy kịch lâm sàng phổ biến với tỷ lệ mắc bệnh và tử vong cao. Nguyên nhân chủ yếu của bệnh đến từ vi khuẩn xâm nhập gây tổn thương mô cục bộ và có thể lan rộng. Cho nên, phương pháp điều trị chính là sử dụng kháng sinh và có thể kết hợp với phẫu thuật.
Xem thêm: Nhiễm virus cytomegalo: Triệu chứng, biến chứng, điều trị và phòng ngừa
Dược sĩ Đại họcNguyễn Mỹ Huyền
Dược sĩ Đại học có nhiều năm kinh nghiệm trong việc tư vấn Dược phẩm và hỗ trợ giải đáp thắc mắc về Bệnh học. Hiện đang là giảng viên cho Dược sĩ tại Nhà thuốc Long Châu.